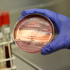

أخرى من منوعات»

اجتماعي / لجنة رعاية السجناء بجازان توزع كسوة العيد
17 أغسطس 2012 15:08
الإفراط في تناول الكولا يؤدي إلى شلل العضلات
17 أغسطس 2012 17:05
وزير بريطاني يتبرع بدماغه
17 أغسطس 2012 17:04
الطيران الحربي الروسي يستعرض مهاراته في أجواء صربيا والصين
17 أغسطس 2012 17:01
فن تنظيف البيت
17 أغسطس 2012 15:11
بكتريا معوية تحدد إمكانية الإصابة بداء السكري
17 أغسطس 2012 14:10
نظام العصابة وسياسة تدبير المكائد
17 أغسطس 2012 14:03
هؤلاء «جابوا العيد» قبل أوانه
17 أغسطس 2012 14:03
إير فرانس تطلب نقوداً من ركابها للتزود بالوقود
17 أغسطس 2012 13:01 لا توجد صوررفع حالة الطوارئ بسبب تحول العاصفة "كاي-تاك" المدارية إلى اعصار
17 أغسطس 2012 05:06 لا توجد صورتعاطي التبغ عادة مترسخة بالدول النامية
17 أغسطس 2012 12:12
مسلسل عمر.. الشاشة أبلغ من الكتاب!!
17 أغسطس 2012 12:09
نجل الرئيس المصري: سافرنا للسعودية على حسابنا الخاص
17 أغسطس 2012 10:14
مصدر إعلامي غير رسمي: بوتين أصبح جداً
17 أغسطس 2012 10:10
زوجان صينيان يسعيان لتغيير جنسيهما واستبدال الأدوار الزوجية
17 أغسطس 2012 09:13
في الاردن: رجل يرتدي خماراً ليسرق مستخدمي الصرافات الآلية
17 أغسطس 2012 07:07
بناء العضلات وإنقاص الوزن لا يحتاجان إلى مشروبات البروتين
17 أغسطس 2012 06:19
الامريكان يبتكرون دواء لتحسين المزاج
17 أغسطس 2012 06:06
قولي للبطن الكبير والارداف الضخمة وداعاً بهذه التمارين
17 أغسطس 2012 06:06
ريجيم ينقصك نص كيلو يومياً
17 أغسطس 2012 06:06
7 حلول للحواجب الخفيفة
17 أغسطس 2012 06:06
تعلمي صنع تارت التمر والكاسترد
17 أغسطس 2012 06:06 لا توجد صورما لا يقل عن 18 شخصا عالقون فى منجم فى شنشى
17 أغسطس 2012 05:06
قرية فرنسية تنظم سباقا للحلزونات! - فيديو
17 أغسطس 2012 04:07
فرحة هستيرية لمشجع صافح ميسي بعد اقتحامه مباراة الأرجنتين وألم...
17 أغسطس 2012 04:07
شاب جزائري يقتل شقيقته بسبب برنامج تلفزيوني
17 أغسطس 2012 04:07
الجريب فروت يعالج السرطان والبدانة
17 أغسطس 2012 03:14
دراسات حديثة حول ذاكرة الأطفال
17 أغسطس 2012 03:02 لا توجد صورأسرار.. لتمتع النساء بنوم جيد أثناء الليل
17 أغسطس 2012 03:02 لا توجد صورهل تريد إجراء حمية غذائية؟عليك ببعض الكعك
17 أغسطس 2012 03:02 لا توجد صورطفرة جينية تقي من مرض ألزهايمر
17 أغسطس 2012 03:02 لا توجد صورالتناول التدريجي قد يقضي على الحساسية من البيض وأنواع الأطعمة ...
17 أغسطس 2012 03:02 لا توجد صوركيف نهيئ الجهاز الهضمي للتغيرات الغذائية في أيام عيد الفطر؟
17 أغسطس 2012 03:02
متسابقة أسيوية تسجل رقما قياسيا فى مسابقة الأكل بنيويورك
17 أغسطس 2012 03:01
الغذاء المتوسطي يقوي العظام
17 أغسطس 2012 03:01
ابتكار أقراص لمنع المني
17 أغسطس 2012 03:01
4 أفكار لإسعاد طفلك في العيد
17 أغسطس 2012 01:07
ألمانيا تحتجز شابا سعوديا كان مسافرا مع أسرته إلى أمريكا
17 أغسطس 2012 01:04
فك شيفرة الإشارات البصرية إلى المخ
17 أغسطس 2012 00:13
techie _ bits مشروع جديد للفتيات السعوديات
17 أغسطس 2012 00:13أخبار ساخنة من منوعات»
جديد من منوعات»
- هل من ترياقات صالحة لعكس مفاعيل الشيخوخة؟ ...
- السعودية تفتح التسجيل في أكبر فعالية أمن س...
- المؤرخ الجزائري: على من تقرأ زابورك يا...؟...
- أفضل طرق لعلاج الخوف والقلق
- نصائح لتناول الفول والطعمية خلال الحمية ال...
- 5 من فوائد فلفل الكايين الصحية المذهلة
- 7 من فوائد بذور الشيا الصحية للجسم
- أفضل 5 مشروبات تشربها على الإفطار
- «عائلة تس» في الرياض و«سوبر ماركت» الخميس
- متطوعون لإصلاح المركبات العالقة بالمطر
- ربى.. آلة تحول الكراتين التالفة لأكياس ورقية
- الاتحاد يواجه العين والجزيرة بمعسكر دبي
- منتخبنا يلعب بالأبيض.. ومناورة تجهزه لفيتنام
- جماهير الفورمولا 1 يتسابقون على حلبة كورني...
- الأردن يطالب بتحقيق للتأكد من جنس حارسة من...
- الأخضر لإحكام القبضة على الصدارة تفوق تاري...
- رينارد: علينا مضاعفة الجهد لتحقيق هدفنا
- المالكي: مبارياتنا المتبقية أشبه بالنهائيات
- وسائل إعلام: توقيف شخص في تركيا يشتبه بضلو...
- نوعان من الأطعمة "الصحية" تحتاج إلى تجنبهم...